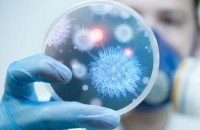

В Ужгороді відбулася ХІІ Міжнародна науково-практична конференція GeoTech Zakarpattya 2025
Форум присвячено важливим ювілейним датам: 80-річчю ДВНЗ «Ужгородський національний університет» та 20-річчю географічного факультету університету, інформує обласна рада.
Новини
- 24.10.2025
- Звільнився з армії – і через місяць повернувся знов: історія військового зі 101 бригади ТрО Закарпаття
- Ветеран-поліцейський із Закарпаття став чемпіоном світу з бойових єдиноборств ICO
- Спортивний рух на Закарпатті - понад 1000 команд вже зареєструвалися на «Пліч-о-пліч Всеукраїнські шкільні ліги»
- Мінветеранів запускає програму адаптації для Захисників і Захисниць, які повністю або частково втратили зір
- В Ужгороді відбулася ХІІ Міжнародна науково-практична конференція GeoTech Zakarpattya 2025
- Закарпатські поліцейські затримали двох зловмисників за переправлення чоловіків через кордон
- 14-ий «Книга-фест» – нині в Ужгороді у «Совиному гнізді»
- На Рахівщині водій, не впоравшись із керуванням, зіткнувся з електричним стовпом та перекинувся
- В Ужгороді виявили громадянина Йорданії, який порушив правила перебування в Україні
- Жорстоке поводження із твариною: прокуратура повідомила про підозру 35-річному закарпатцю
- Понад 200 юних спортсменів змагаються у відкритому чемпіонаті Ужгорода з плавання
- Пам'ять жертв Угорської революції проти комуністичної диктатури вшанували в обласному центрі Закарпаття
- «Тут шанують ветеранів»: Ужгород приєднується до всеукраїнського руху підтримки захисників
- До уваги закарпатських студентів: відкрито набір на School of Resilience — безкоштовний проєкт для особистісного розвитку молоді
- Які штами грипу циркулюватимуть в Закарпатті, чи зафіксовані вже випадки і коли чекати на епідемію
- Скільки закарпатці платитимуть за електроенергію цієї зими?
- 23.10.2025
- "Я не вважаю це героїчним вчинком": ужгородка Крістіна Петрулич розповіла про нагороду "Герой-рятувальник року"
- Патрон Флобера: маленька деталь великої точності
- Простір підтримки і відновлення: на Закарпатті допомагають військовим повернути рівновагу
- 34 000 грн штрафу сплатить перевізник, водій якого на Закарпатті використовував чип-картку іншого водія
- Ужгородців попереджають про проведення 24–25 жовтня заходів із винищення гризунів
- У Шахтинському лісі в Ужгороді вперше проведуть благодійний забіг «UZHTRAIL 2025»
- Закарпатська служба зайнятості пропонує понад 1500 вакансій із середньою зарплатою 13,5 тис. грн
- «Бограч-index» – жовтень 2025: за місяць ціни за продукти змінилися на - 2,1%
- Стань частиною прикордонної команди: на Закарпатті презентували можливості служби за контрактом
- На Закарпатті викрито групу осіб, які налагодили незаконний «бізнес» із продажу підакцизних товарів
- На Закарпатті вручили державну нагороду рідним полеглого прикордонника Дмитра Цацури
- Міст, що залишається навіть у складні часи – ЄОТС ТИСА виповнилося десять років
- Прокурори Закарпаття обговорили розширення та зміцнення співпраці з КМЄС
- Ще 6 мільйонів гривень на підтримку Збройних Сил України виділили із бюджету Ужгорода